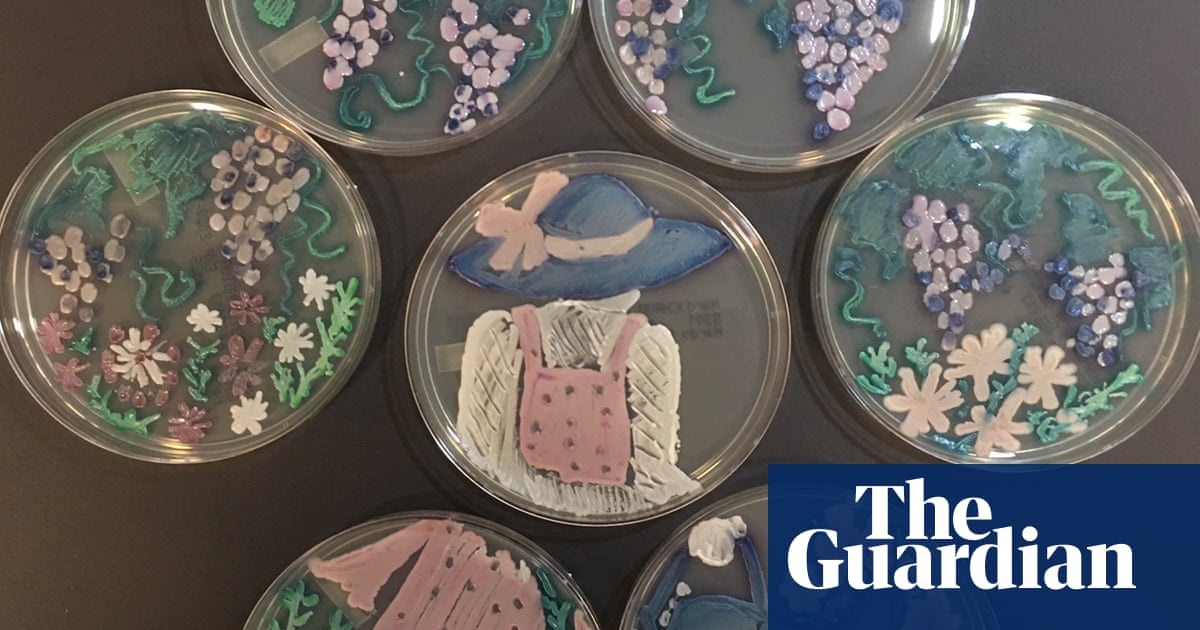
Art in a petri dish: the Agar art awards 2020 – in pictures | Science

Wallpapers are a type of photo wallpaper that can be found in many different places online. They are any type of image that is put on the wall and can be used as a background image or to add some Personality to an office.
searching about 16 Amazing 3D Game Character Design Masterpieces and Tips for you’ve came to the right web. We have 16 Images about 16 Amazing 3D Game Character Design Masterpieces and Tips for like Fashion sketch apps recommendations and examples, plus tutorials, Download Fashion Sketches 8 and also Download Fashion Sketches 8. Read more:
16 Amazing 3D Game Character Design Masterpieces And Tips For

Source: templatesperfect.com
character masterpieces alien escorte superheroes heroines plethora putas unei povestea sibiu.
Wallpapers are a type of photo wallpaper that can be found in many different places online. They are any type of image that is put on the wall and can be used as a background image or to add some Personality to an office.
Fashion Design App Free / 13 Apps Fashion Designers Need To Maximize
Source: gingerexpression.blogspot.com
.
How to Choose the Right Wallpaper for Your Home: Factors to Consider When it comes to wallpaper, there are a few things that you need to take into account before making your decision. The first and most important factor is the size of your room. A wallpaper with a large image will not fit well in a small room, and vice versa. The second thing that you need to consider is the color of your home’s walls. If you want a wallpapers to be noticed, you’ll want to choose something that complements your home’s natural colors. However, if your walls are light brown or white, then a darker color may work better. Lastly, the quality of the wallpaper should be considered. Some people find that prints or photos will not show as well on high-quality wallpaper than others.
Download Fashion Sketches 8

Source: fashion-sketches.soft32.com
fashion sketches screenshots windows.
Gallery: A showcase of some beautiful wallpaper designs. Looking for a new wallpaper design to add to your collection? Check out Gallery A, where you can see some stunning wallpaper designs. From simple designs that are perfect for any room to bold and exciting designs, there is something for everyone. With such a wide range of styles, it’s sure to be an interesting and engaging browsing experience. Whether you’re looking for a new way to display your walls or just want some new inspiration, Gallery A is the perfect place to go!
10 Styles For Y2K Outfits 1999s Street Style | Y2k Fashion Early 2000s

Source: pinterest.com
y2k emo 1999s.
How to Choose the Right Wallpaper for Your Home: Factors to Consider When it comes to wallpaper, there are a few things that you need to take into account before making your decision. The first and most important factor is the size of your room. A wallpaper with a large image will not fit well in a small room, and vice versa. The second thing that you need to consider is the color of your home’s walls. If you want a wallpapers to be noticed, you’ll want to choose something that complements your home’s natural colors. However, if your walls are light brown or white, then a darker color may work better. Lastly, the quality of the wallpaper should be considered. Some people find that prints or photos will not show as well on high-quality wallpaper than others.
Fashion_Designer_Sketch_4_-Fashion_Design_Software-_Digital_Fashion

Source: startmyline.com
fashion designer digital sketch software pro reply address cancel leave email.
Anime wallpaper is a popular trend in the internet. It can be a great way to add some extra color or interest to your desktop. There are many different types of anime wallpaper, so it’s important to find the one that fits your own style and needs.
Fashion Sketch Apps Recommendations And Examples, Plus Tutorials

Source: fashionillustrationtribe.com
fashion sketch apps procreate app.
Art In A Petri Dish: The Agar Art Awards 2020 – In Pictures | Science
Source: theguardian.com
petri.
Wallpapers are a great way to set the tone of a room or home. They can also be used as an easy way to add personality and style to a room.
Sketch Fashion App For Android

Source: bekomes.co
.
Anime wallpaper is a popular way to show off your love of anime in a visual way. There are many different types of anime wallpaper, from classic cel-shading to realistic graphics. Whether you’re looking for something traditional or futuristic, there’s always something to choice from.
CHASSEUR INTERVIEWS ARTIST SANDRA CHEVRIER - Chasseur Magazine

Source: chasseurmagazine.com
chevrier chasseur antony mort laissant entrer fubiz.
What are the benefits of cool wallpaper? Wallpaper can be a great addition to any room. It can add some visual interest and make a home feel more inviting. There are a variety of cool wallpaper options available, so it’s important to find the right one for your needs. Here are some benefits of using cool wallpaper:
Cool wallpaper can add an air of chill. When you have a wall full of cool wallpaper, it can help create a feeling of chilled outness in the room. This can make you feel more relaxed and allow you to relax more when you’re home.
Cool wallpaper is perfect for bedrooms and other areas that need some lightness in the space. A lot of people find cool wallpaper goes well with dark walls because it makes everything pop together better.
Cool wallpaper is often affordable and easy to get installed on your wall!
Fashion Design Sketch Ideas - Apps On Google Play
Source: play.google.com
fashion sketch.
cool wallpaper and home design ideas are very popular these days. There are so many choices to choose from, and it can be fun to find a wallpaper that you like and make your home look good. There are many differentwallpaper designs to choose from, so it is important to find one that will fit your house and style.
Best Fashion Illustration Apps

Source: ruangbelajar-316.blogspot.com
.
One of the most popular resolutions for desktop wallpaper is 1280x1024. This resolution is commonly used on laptops and moderndesktop computers, and offers a great image quality.
Model @bianca_cadar #2882383

Source: litmind.com
cadar.
Gallery: A showcase of some beautiful wallpaper designs. Looking for a new wallpaper design to add to your collection? Check out Gallery A, where you can see some stunning wallpaper designs. From simple designs that are perfect for any room to bold and exciting designs, there is something for everyone. With such a wide range of styles, it’s sure to be an interesting and engaging browsing experience. Whether you’re looking for a new way to display your walls or just want some new inspiration, Gallery A is the perfect place to go!
Akira Kurosawa: From Samurais To Shakespeare

Source: theculturetrip.com
akira kurosawa japanese 1953 samurai film japan seven wikipedia.
What is anime and why are people interested in it? Anime is a genre of animation that typically follows the story lines of young people in Japan. It has been around since the late 1800s and has seen many changes over the years. One of the most recent changes is that anime has become more popular than ever, with people from all walks of life becoming interested in it. This popularity can be seen in its various forms, from traditional Toonami programming to online streaming services. There are many reasons people may enjoy anime, but one of the most important reasons is because it provides an escape from reality.
9/11 Remembrances: On The 13th Anniversary, America Reflects — Pictures

Source: theguardian.com
.
When it comes to desktop wallpaper, there are a variety of options to choose from. A few popular choices include: HD wallpaper, retina wallpaper, and high definition wallpaper. All of these Wallpapers come in a variety of resolutions, which can make them perfect for any desktop or mobile device.
Best Fashion Drawing Apps For Ipad - Fashion And Wedding Ideas

Source: kotayogyakarta.com
.
When it comes to desktop wallpaper, there are a variety of options to choose from. A few popular choices include: HD wallpaper, retina wallpaper, and high definition wallpaper. All of these Wallpapers come in a variety of resolutions, which can make them perfect for any desktop or mobile device.
Portfolio: Poster Designing | PGBS

Source: proglobalbusinesssolutions.com
poster designing posters perform perfectly promote custom.
Anime Characters and their Designs: Most animes feature colorful characters with distinctive designs. There are a variety of anime characters and their designs that can be seen on many different screens. Some of the most popular and well-known anime character designs include those of Naruto, One Piece, and Attack on Titan. The designs for these characters are often complex and colorful, making them some of the most recognizable in the industry. This popularity is likely due to their uniqueness as well as the intricate details that go into their design.